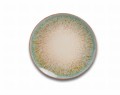
lubiana kerajet 9017 eskot krakow_14.jpg

Zestaw talerzy Lubiana 6/18 KERAJET 9017 18 sztuk Turquesa
Cena regularna:
Cena regularna:
towar niedostępny
 dodaj do przechowalni
dodaj do przechowalni
 Opis
Opis
Zestaw 6/18 talerzy Kerajet Turquesa
Najnowsza pozycja z fasonu Boss - kolekcja KERAJET.
- Talerze z tej linii zapewniają komfort, funkcjonalność i wygodę użytkowania.
- Naczynia, wykonane z wysokiej jakości porcelany, doskonale sprawdzą się w każdym wnętrzu.
- Uwagę przykuwa nowoczesne wzornictwo, zachowując przy tym przystępne ceny.
- Znajdują zastosowanie jako zastawa do codziennego użytkowania jak również na specjalne okazje
- Polecane do zastosowań domowych jak również w restauracjach, hotelach i innych obiektach gastronomicznych
Właściwości:
- nadaje się do zmywarek, piekarników i kuchenek mikrofalowych
- kolor 9017 - Turquesa
- porcelana Lubiana
W skład zestawu wchodzi:
- 6x talerz deserowy 20,5 cm
- 6x talerz płytki 27 cm
- 6x talerz głęboki 22 cm
 Koszty dostawy
Cena nie zawiera ewentualnych kosztów płatności
Koszty dostawy
Cena nie zawiera ewentualnych kosztów płatności
 Opinie o produkcie (0)
Opinie o produkcie (0)
 Zaloguj się
Zaloguj się
 Darmowa dostawa
Darmowa dostawa